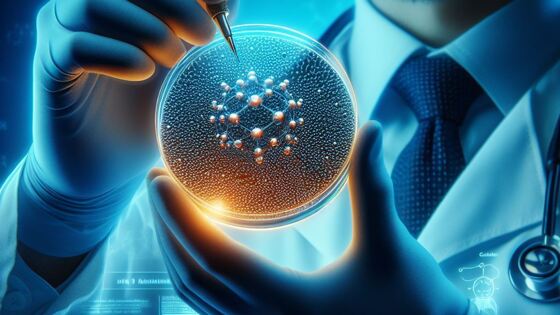

Российские учёные создали керамику, которая изменит дисплеи навсегда
Представьте себе мир, где экраны смартфонов сияют ярче солнца, а картинка настолько чёткая, что кажется, будто смотришь в окно. Фантастика? Возможно, но российские изобретатели уже близки к этой реальности. Учёные Уральского федерального университета совместно с коллегами из Индии и Уральского отделения РАН создали уникальную нанокерамику, которая может перевернуть мир дисплеев.
Вы когда-нибудь задумывались, как создаются экраны наших любимых смартфонов? Это целая наука, в которой инженеры постоянно ищут новые революционные решения. И вот, российским учёным удалось разработать нечто поистине грандиозное — новую керамику, которая способна навсегда изменить мир дисплеев.
Все началось с команды исследователей из Уральского федерального университета (УрФУ), Института химии твёрдого тела УрО РАН и коллег из Индии. Ребята потрудились на славу и создали керамику, которая светиться тремя основными цветами: красным, зелёным и синим.
Казалось бы, что в этом такого? Ведь именно комбинация этих трёх цветов и используется в современных дисплеях для получения всей гаммы оттенков. Но дьявол кроется в деталях.

Светящиеся кристаллы
Уникальность разработки российских учёных заключается в том, что они использовали особый материал — алюмо-магниевую шпинель, который имеет кубическую кристаллическую решетку: свет, который проходит сквозь него, не преломляется и не рассеивается.
А главное, если добавить частиц углерода, керамика начинает люминесцировать — то есть излучать свет.

Учёные выбрали алюмо-магниевую шпинель из-за её уникальным свойств, которые идеально подходят для производства дисплеев.
Во-первых, она светится тремя основными цветами — красным, зелёным и синим. Во-вторых, материал этот невероятно прочный, так как создана под высоким давлением. И в-третьих, она прозрачная.
Кстати, хотя у кристаллов кубической сингонии коэффициент преломления не зависит от направления, свет всё же может преломляться, если падает под углом. К тому же, на границах зёрен керамики и при наличии дефектов в кристаллах свет будет рассеиваться, независимо от структуры.
Ключевой элемент этой инновационной технологии — углеродные наноточки. Эти микроскопические кластеры углеродных атомов обладают уникальной способностью светиться разными цветами (в зависимости от своего размера и структуры).
Учёные смогли «запечатать» эти наноточки внутри керамической матрицы и создали материал, который не только светится, но и обладает высокой прочностью и прозрачностью.
Мы получили оптически прозрачную нанокерамику, которая способна люминесцировать красным, зелёным и синим цветами. Это стало возможным благодаря добавлению частиц углерода, которые выступили в качестве углеродных наноточек. В процессе синтеза углеродные компоненты становятся заключёнными между частицами керамики, что образует дефекты на их поверхности. Мы полагаем, что эти дефекты создают ряд энергетических уровней в углеродных наноточках, благодаря чему материал может светиться разными цветами в видимом спектрерсений Киряков доцент кафедры физических методов и приборов контроля качества УрФУ
Особая структура наноточек и активная поверхность позволяют им светиться с удивительной эффективностью (до 70%), что делает их идеальным материалом для создания ярких и красочных дисплеев.
А это означает, что дисплеи на основе такой керамики смогут иметь гораздо большую плотность пикселей и сохранять при этом высокую яркость.

Прощай, пиксель!
В традиционных дисплеях каждый пиксель — просто точка, которая меняет свой цвет. Чем больше пикселей, тем ниже их яркость. В новой технологии каждый пиксель — микроскопический светодиод, созданный из нанокерамики.
Такой подход позволяет добиться невероятной чёткости изображения и яркости, недоступной для современных дисплеев.
Поскольку наша нанокерамика способна обеспечить все три базовых цвета спектра (красный, зелёный и синий), то нет необходимости использовать три светодиода по отдельности — достаточно будет разместить на светоизлучающем чипе один элемент для получения всех трёх цветов. Также благодаря тому, что синтез керамики осуществлён под высоким давлением, наночастицы расположены друг к другу очень плотно — это позволило избавиться от дефектов, добиться оптической прозрачности и повысить прочность. Такие характеристики будут полезны для производства дисплеев смартфонов и планшетов, поскольку повышенная концентрация углеродных наноточек позволит увеличить эффективность свечения, что может способствовать росту плотности пикселей в дисплее на единицу площади.лия Кузнецова доцент кафедры физических методов и приборов контроля качества УрФУ
Чтобы по-настоящему проникнуться важностью этого открытия, стоит вспомнить историю создания светодиодов — краеугольного камня современных дисплеев.

Первые шаги в этом направлении были сделаны ещё в 1927 году советским физиком Олегом Лосевым, который обнаружил явление электролюминесценции в карбиде кремния. Но из-за начала Второй мировой войны учёный не смог продолжить свои исследования.
Во время многодневной блокады Ленинграда сотни тысяч горожан, в том числе и Олег, скончались от голода. Он умер 22 января 1942 года.

Только в 1960-х годах, после того как американец Ник Холоньяк «заново открыл» патент Лосева, интерес к светодиодному освещению возродился. В 1962 году Холоньяк создал первую рабочую светодиодную лампу и положил начало новой эре в истории освещения.
Были созданы первые красные, зелёные и синие светодиоды, комбинация которых и легла в основу современных экранов.
Кстати, вклад Олега Лосева был настолько значительным, что на протяжении пятидесяти лет светодиоды называли «свечением Лосева», и только в 1974 году они получили своё нынешнее название.
На сегодняшний день светодиоды используются повсеместно — от экранов смартфонов до энергоэффективных осветительных приборов.
От горшков до нанотехнологий
Итак, керамика — это не только бабушкины горшки и тарелки. Её свойства — прочность, жаростойкость, устойчивость к химическим воздействиям — позволяют использовать керамику во многих сферах, от строительства до медицины.
А теперь, благодаря российским учёным, керамика готова покорить и мир высоких технологий.

Наши физики уже запатентовали свою разработку и активно ведут переговоры с производителями электроники. Так что скоро мы сможем увидеть революционные дисплеи в наших любимых гаджетах.
Технологический прогресс не стоит на месте, и этот проект — яркое тому подтверждение.
И если перспектива супер-ярких и чётких дисплеев на основе нанокерамики вас не впечатлила, то вот вам ещё один пример того, как этот удивительный материал меняет мир технологий.
Совместно с Китаем
Российские и китайские учёные объединили усилия, чтобы разработать новую бессвинцовую электрострикционную керамику, которая не только безопасна для окружающей среды, но и в три раза эффективнее существующих аналогов.

Эта инновационная керамика, которая состоит из бария, кальция, титана и олова, способна изменять свои размеры под воздействием электрического поля. Такое свойство делает её идеальным материалом для создания адаптивной оптики, применяемой в наземных телескопах.
Адаптивная оптика позволяет корректировать искажения изображения, которые вызывают колебаниям плотности воздуха в атмосфере, что существенно повышает качество наблюдений за небесными телами.
Мы уверены, что дальнейшие совместные исследования помогут создать электрострикционный материал, который сможет заменить опасную для окружающей среды керамику для создания современных электронных устройств, а также будет востребована астрономамиладимир Шур директор УЦКП «Современные нанотехнологии» УрФУ
Совместный проект учёных Уральского федерального университета и Сианьского транспортного университета открывает новые возможности для астрономии. С помощью такой керамики можно изготовить более точные и экологичные телескопы.

Конечно, путь от лабораторных исследований до массового производства долгий и сложный. Но первые шаги уже сделаны, и перспективы выглядят многообещающими: открытия эти вполне могут стать основой для создания новых высокотехнологичных продуктов.
Так что следите за новостями, возможно, уже скоро вы будете держать в руках смартфон с экраном, который создан из российской нанокерамики (или глядеть в новенький телескоп).
И тогда вы сможете сказать: «Мир менялся на моих глазах!»


